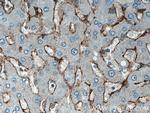
SEC63 Antibody in Immunohistochemistry (Paraffin) (IHC (P))

Search
Proteintech
SEC63 Polyclonal Antibody
{{$productOrderCtrl.translations['antibody.pdp.commerceCard.promotion.promotions']}}
{{$productOrderCtrl.translations['antibody.pdp.commerceCard.promotion.viewpromo']}}
{{$productOrderCtrl.translations['antibody.pdp.commerceCard.promotion.promocode']}}: {{promo.promoCode}} {{promo.promoTitle}} {{promo.promoDescription}}. {{$productOrderCtrl.translations['antibody.pdp.commerceCard.promotion.learnmore']}}
产品信息
13978-1-AP
种属反应
已发表种属
宿主/亚型
分类
类型
抗原
偶联物
形式
浓度
规格
纯化类型
保存液
内含物
保存条件
运输条件
产品详细信息
Immunogen sequence: IQDLVSLKE SDRHTLLHFL EDEKYEEVMA VLGSFPYVTM DIKSQVLDDE DSNNITVGSL VTVLVKLTRQ TMAEVFEKEQ SICAAEEQPA EDGQGETNKN RTKGGWQQKS KGPKKTAKSK KKKPLKKKPT PVLLPQSKQQ KQKQANGVVG NEAAVKEDEE EVSDKGSDSE EEETNRDSQS EKDDGSDRDS DREQDEKQNK DDEAEWQELQ QSIQRKERAL LETKSKITHP VYSLYFPEEK QEWWWLYIAD RKEQTLISMP YHVCTLKDTE EVELKFPAPG KPGNYQYTVF LRSDSYMGLD QIKPLKLEVH EAKPVPENHP QWDTAIEGDE DQEDSEGFED SFEEEEEEEE DDD (409-760 aa encoded by BC047221)
靶标信息
SEC63 gene ontology annotations related to this gene include liver development; multicellular organism aging; nitrogen compound metabolic process; posttranslational protein targeting to endoplasmic reticulum membrane; posttranslational protein targeting to membrane, translocation; renal system development; SRP-dependent cotranslational protein targeting to membrane.
仅用于科研。不用于诊断过程。未经明确授权不得转售。
生物信息学
蛋白别名: DnaJ homolog subfamily C member 23; SEC63 homolog (S. cerevisiae) isoform SEC63_1; SEC63 homolog (S. cerevisiae) isoform SEC63_2; SEC63 protein translocation regulator; SEC63-like protein; similar to Saccharomyces cerevisiae Sec63p; Translocation protein SEC63 homolog; unnamed protein product
基因别名: 5730478J10Rik; AI649014; AW319215; DNAJC23; ERdj2; PCLD2; PRO2507; SEC63; SEC63L
UniProt ID: (Human) Q9UGP8, (Mouse) Q8VHE0
Entrez Gene ID: (Human) 11231, (Rat) 309858, (Mouse) 140740